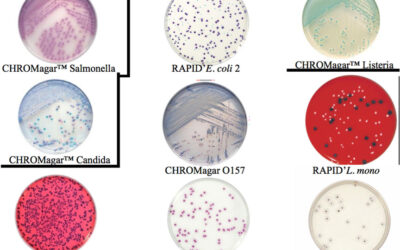
Seminar “Health dangers in Hotels”

Celebrating the New Year
The AgroSpeCom team celebrated the New Year with the traditional Vasilopita event, on January 26, 2017.
Control Union involved in improving Hygiene in Refugee Camps
Recently AgroSpeCom / Control Union Greece applied our HEAT TREATMENT technique in a new and unique, but simultaneously miserable, environment; a temporary residency for refugees in Northern Greece.
CAF 2016, New Delhi
The Controlled Atmosphere and Fumigation conference is taking place this year in India and Vasilis Sotiroudas of Control Union Greece is giving a presentation on Phosphine treatment under low pressure.
Heat treatment, Low Oxygen and Phosphine is on the menu, making this conference the most important international event in precision fumigation.
AgroSpeCom is fighting against the deadliest creatures on Earth!
Cnet.com has recently released the ranking of the 24 deadliest creatures on Earth. The list proves why AgroSpeCom is fighting on daily basis against 9 of them!
Go through the list with us to experience the threats and challenges our men confront in remote locations, silos, houses, rivers and lakes around Greece!
Cashew World Conference: Vasilis Sotiroudas presentation
Vasilis Sotiroudas ,the manager of AgroSpeCom, presented on “Intelligent Fumigations” in the Cashew World Conference in Dubai on February 18-20, 2016. To conference presentation click here. More information on this conference can be found here:...
Seminar “Health dangers in Hotels”
AgroSpeCom organizes the seminar “Health dangers in Hotels” in Park Hotel, Volos, on May 16th, 2016. This high quality seminar specializes on health and hygiene problems in hotels, offering solutions and preventive measures. Dr. Christos Athanasiou professor of...